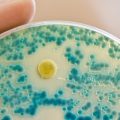
Antibiyotiğe karşı dirençli bakteriler yüzünden 1,2 milyon kişi hayatını kaybetti

Murat Altaş
Uzun yaşamak ister miydiniz? Bilim dünyası ölüme meydan okuyor!
Tüm okurlarımıza merhaba, Umarım sağlığınız iyidir ve ömrünüz boyunca da böyle kalır. Bu girizgahtan yola çıkarak, ortaya bir soru atalım: “Yaşlanmamak ve uzun yaşamak ister miydiniz?” Çoğunuz için bu...
HBT Dergi 308. sayı – 17 Şubat 2022
Bilim dünyası ölüme meydan okuyor Hangi uygarlık? Barış neden olmuyor? En kötü insanlık suçu ne? - Doğan Kuban Sinema ve nöroloji - Özlem Kayım Yıldız Enerji; teşvikler, Ar-Ge - Ali Akurgal Edebiyatın...
NASA’dan 2 yeni Güneş görevi
ABD Havacılık ve Uzay Ajansı NASA’dan yapılan açıklamada, Güneş’in dinamiklerini, Güneş-Dünya bağlantısını ve sürekli değişen uzay ortamını anlamaya yardımcı olmasına yönelik MUSE (Multi-slit Solar Ex...
Mikroorganizmalarda hızlı evrime dair yeni model
Avusturyalı ve Finli araştırmacılar, mikroorganizmalarda da tıpkı yırtıcılar ve avlar arasında olduğu gibi karşılıklı etkileşim olduğunu yeni bir modelle gösterdiler. Yırtıcı avcı ve av arasındaki ili...
İlk melez hayvanın fosili bulundu: 4500 yıllık bir eşek
Suriye’nin Halep kentinde araştırmacılar alışılmışın dışında bir eşek kalıntısı buldular. Ayrıntılı incelemeler sonucunda 4500 yıllık fosilin bilinen en eski eşek melezi olduğu anlaşıldı. Arkeologlar ...